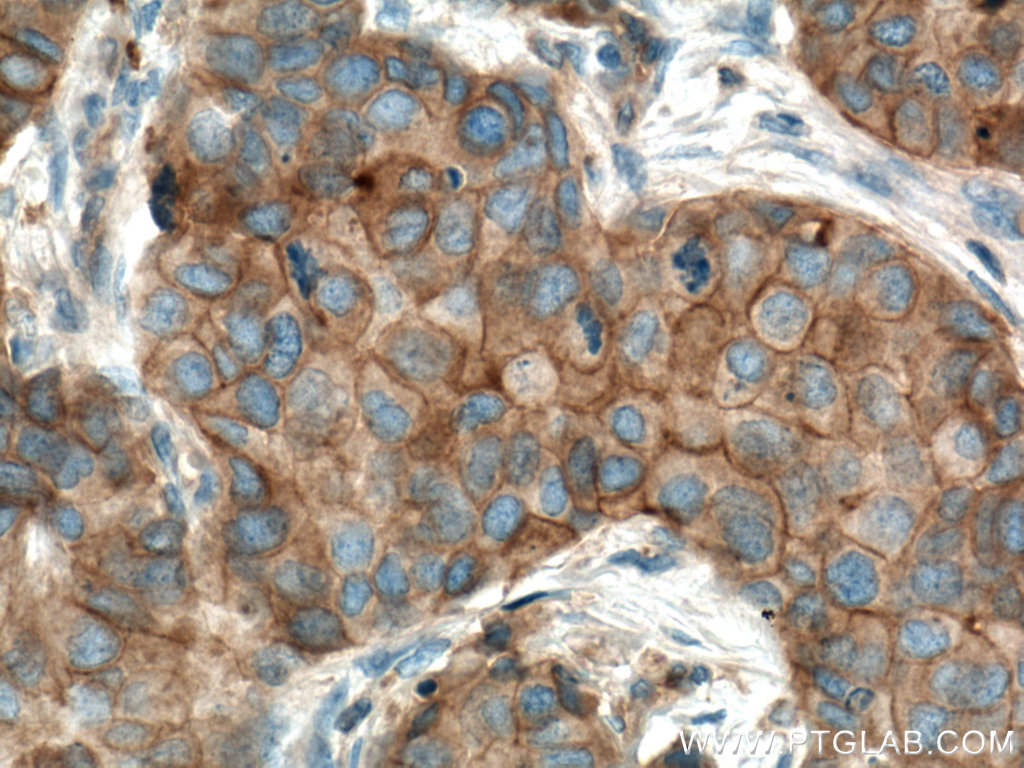

验证数据展示
经过测试的应用
| Positive WB detected in | HEK-293 cells, HeLa cells, HSC-T6 cells, Jurkat cells, MCF-7 cells, NIH/3T3 cells, Ramos cells, PC-12 cells, 4T1 cells |
| Positive IHC detected in | human tonsillitis tissue, human breast cancer tissue Note: suggested antigen retrieval with TE buffer pH 9.0; (*) Alternatively, antigen retrieval may be performed with citrate buffer pH 6.0 |
| Positive IF/ICC detected in | Neuro-2a cells |
| Positive FC (Intra) detected in | HeLa cells |
推荐稀释比
| 应用 | 推荐稀释比 |
|---|---|
| Western Blot (WB) | WB : 1:5000-1:30000 |
| Immunohistochemistry (IHC) | IHC : 1:2000-1:5000 |
| Immunofluorescence (IF)/ICC | IF/ICC : 1:400-1:1600 |
| Flow Cytometry (FC) (INTRA) | FC (INTRA) : 0.25 ug per 10^6 cells in a 100 µl suspension |
| It is recommended that this reagent should be titrated in each testing system to obtain optimal results. | |
| Sample-dependent, Check data in validation data gallery. | |
产品信息
66606-1-Ig targets FYN in WB, IHC, IF/ICC, CoIP, ELISA applications and shows reactivity with human, mouse, rat samples.
| 经测试应用 | WB, IHC, IF/ICC, ELISA Application Description |
| 文献引用应用 | WB, IHC, IF, CoIP |
| 经测试反应性 | human, mouse, rat |
| 文献引用反应性 | human, mouse, rat |
| 免疫原 |
CatNo: Ag11127 Product name: Recombinant human FYN protein Source: e coli.-derived, PET28a Tag: 6*His Domain: 231-483 aa of BC032496 Sequence: YSGTWNGNTKVAIKTLKPGTMSPESFLEEAQIMKKLKHDKLVQLYAVVSEEPIYIVTEYMNKGSLLDFLKDGEGRALKLPNLVDMAAQVAAGMAYIERMNYIHRDLRSANILVGNGLICKIADFGLARLIEDNEYTARQGAKFPIKWTAPEAALYGRFTIKSDVWSFGILLTELVTKGRVPYPGMNNREVLEQVERGYRMPCPQDCPISLHELMIHCWKKDPEERPTFEYLQSFLEDYFTATEPQYQPGENL 种属同源性预测 |
| 宿主/亚型 | Mouse / IgG1 |
| 抗体类别 | Monoclonal |
| 产品类型 | Antibody |
| 全称 | FYN oncogene related to SRC, FGR, YES |
| 别名 | 1G4B1, EC:2.7.10.2, p59 Fyn, p59-Fyn, Proto oncogene c Fyn |
| 计算分子量 | 537aa,61 kDa; 482aa,55 kDa |
| 观测分子量 | 60 kDa |
| GenBank蛋白编号 | BC032496 |
| 基因名称 | FYN |
| Gene ID (NCBI) | 2534 |
| RRID | AB_2881966 |
| 偶联类型 | Unconjugated |
| 形式 | Liquid |
| 纯化方式 | Protein G purification |
| UNIPROT ID | P06241 |
| 储存缓冲液 | PBS with 0.02% sodium azide and 50% glycerol, pH 7.3. |
| 储存条件 | Store at -20°C. Stable for one year after shipment. Aliquoting is unnecessary for -20oC storage. |
背景介绍
FYN, also named p59-Fyn and SLK, belongs to the protein kinase superfamily, Tyr protein kinase family and SRC subfamily. FYN is implicated in the control of cell growth. It plays a role in the regulation of intracellular calcium levels, with isoform 2 showing the greater ability to mobilize cytoplasmic calcium in comparison to isoform 1. FYN is required in brain development and mature brain function with important roles in the regulation of axon growth, axon guidance, and neurite extension. FYN blocks axon outgrowth and attraction induced by NTN1 by phosphorylating its receptor DDC.
实验方案
| Product Specific Protocols | |
|---|---|
| IF protocol for FYN antibody 66606-1-Ig | Download protocol |
| IHC protocol for FYN antibody 66606-1-Ig | Download protocol |
| WB protocol for FYN antibody 66606-1-Ig | Download protocol |
| Standard Protocols | |
|---|---|
| Click here to view our Standard Protocols |
发表文章
| Species | Application | Title |
|---|---|---|
EBioMedicine Obesity induces preadipocyte CD36 expression promoting inflammation via the disruption of lysosomal calcium homeostasis and lysosome function. | ||
EBioMedicine Biallelic mutations in LAMA5 disrupts a skeletal noncanonical focal adhesion pathway and produces a distinct bent bone dysplasia. | ||
Inflammation hPMSCs Regulate the Level of TNF-α and IL-10 in Th1 Cells and Improve Hepatic Injury in a GVHD Mouse Model via CD73/ADO/Fyn/Nrf2 Axis | ||
Biochem Pharmacol PIKE-A promotes glioblastoma growth by driving PPP flux through increasing G6PD expression mediated by phosphorylation of STAT3. | ||
Front Oncol A four oxidative stress gene prognostic model and integrated immunity-analysis in pancreatic adenocarcinoma | ||
ACS Omega Catalpol Promotes Osseointegration of Titanium Implants under Conditions of Type 2 Diabetes via AKT/GSK3β/FYN Pathway-Mediated NRF2 Activation |